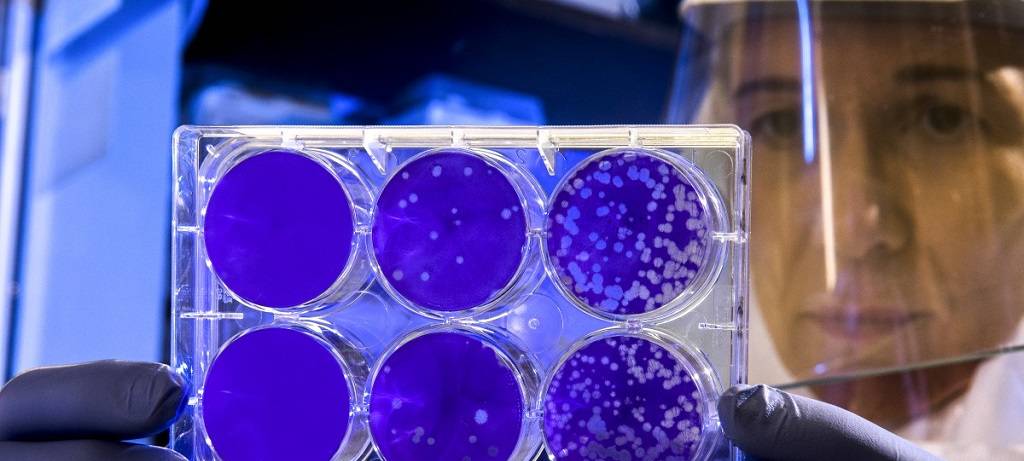
Corona-Mutationen

Corona-Mutationen sind im ländlichen Raum weniger verbreitet als im städtischen Ballungsraum. Das zeigen erste weitestgehend repräsentative Ergebnisse einer Studie der Uniklinik Münster. Gut 900 positive SARS-CoV-2 Proben sind ausgewertet – die erste bundeslandweite Untersuchung in Deutschland. NRW-weit liegt derzeit bei 9% der Corona-Fälle eine Mutation vor, überwiegend die britische Variante. Die südamerikanische Mutation ist in NRW bisher nicht nachgewiesen.
Gesundheitsminister Laumann: Ballungsräume anfälliger für Verbreitung
„Wo viele Menschen aufeinandertreffen und die Bevölkerungsdichte hoch ist, verbreitet sich das Virus schneller,“ sagt Gesundheitsminister Karl-Josef Laumann, "egal ob Mutation oder die uns bekannte Variante." Sobald ein Verdacht auf eine Mutation vorliegt, werden die Fälle in den Gesundheitsämtern vorrangig bearbeitet.“ NRW-weit sind bislang 60 verschiedene Corona-Varianten aufgetreten, darunter die britische (B.1.1.7) in 73 Proben und die südafrikanische (B.1.351) in fünf Proben. Ländliche Regionen, auch die Grenzregion zu den Niederlanden, sind weniger betroffen.